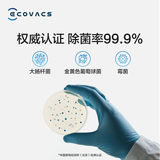

- Таобао
- Техника
- Бытовая техника
- Электрические щетки для уборки
- 637023817157
Kobos N8 Scan Robot Intelligence

Цена: 31 375-33 886руб. (¥1499)
Артикул: 637023817157
Вес товара: ~0.7 кг. Указан усредненный вес, который может отличаться от фактического. Не включен в цену, оплачивается при получении.
Описание товараPGRpdj48aW1nIHNyYz0iaHR0cHM6Ly9pbWcuYWxpY2RuLmNvbS9pbWdleHRyYS9pNC81MDg0Mjg2NS9PMUNOMDFhUmRWQTgxWDJETno1OEE5eF8hITUwODQyODY1LmpwZyI+PC9kaXY+PGRpdj48aW1nIHNyYz0iaHR0cHM6Ly9pbWcuYWxpY2RuLmNvbS9pbWdleHRyYS9pNC81MDg0Mjg2NS9PMUNOMDFvQ01Nc0IxWDJETzE1SW9BNV8hITUwODQyODY1LmpwZyI+PC9kaXY+PGRpdj48aW1nIHNyYz0iaHR0cHM6Ly9pbWcuYWxpY2RuLmNvbS9pbWdleHRyYS9pMS81MDg0Mjg2NS9PMUNOMDFGdkdmYXMxWDJETzBhdDAzMF8hITUwODQyODY1LmpwZyI+PC9kaXY+PGRpdj48aW1nIHNyYz0iaHR0cHM6Ly9pbWcuYWxpY2RuLmNvbS9pbWdleHRyYS9pMi81MDg0Mjg2NS9PMUNOMDFTdFlXaWMxWDJETnVUeVFqSF8hITUwODQyODY1LmpwZyI+PC9kaXY+PGRpdj48aW1nIHNyYz0iaHR0cHM6Ly9pbWcuYWxpY2RuLmNvbS9pbWdleHRyYS9pMi81MDg0Mjg2NS9PMUNOMDFid0FPZWExWDJETnVUeVoxTF8hITUwODQyODY1LmpwZyI+PC9kaXY+PGRpdj48aW1nIHNyYz0iaHR0cHM6Ly9pbWcuYWxpY2RuLmNvbS9pbWdleHRyYS9pNC81MDg0Mjg2NS9PMUNOMDFJMTB3TDYxWDJETno1OWx5UF8hITUwODQyODY1LmpwZyI+PC9kaXY+PGRpdj48aW1nIHNyYz0iaHR0cHM6Ly9pbWcuYWxpY2RuLmNvbS9pbWdleHRyYS9pMS81MDg0Mjg2NS9PMUNOMDFiNGY3MEcxWDJETnZic0lXU18hITUwODQyODY1LmpwZyI+PC9kaXY+PGRpdj48aW1nIHNyYz0iaHR0cHM6Ly9pbWcuYWxpY2RuLmNvbS9pbWdleHRyYS9pMS81MDg0Mjg2NS9PMUNOMDF3SmExVEcxWDJETnM0eG4xTl8hITUwODQyODY1LmpwZyI+PC9kaXY+PGRpdj48aW1nIHNyYz0iaHR0cHM6Ly9pbWcuYWxpY2RuLmNvbS9pbWdleHRyYS9pNC81MDg0Mjg2NS9PMUNOMDFtcUNsenQxWDJETnd5TmJqOV8hITUwODQyODY1LmpwZyI+PC9kaXY+PGRpdj48aW1nIHNyYz0iaHR0cHM6Ly9pbWcuYWxpY2RuLmNvbS9pbWdleHRyYS9pNC81MDg0Mjg2NS9PMUNOMDFYdWUyYW4xWDJETnpoZ0RWRl8hITUwODQyODY1LmpwZyI+PC9kaXY+PGRpdj48aW1nIHNyYz0iaHR0cHM6Ly9pbWcuYWxpY2RuLmNvbS9pbWdleHRyYS9pMy81MDg0Mjg2NS9PMUNOMDFKdHlsdk0xWDJETnVUdzVEQ18hITUwODQyODY1LmpwZyI+PC9kaXY+PGRpdj48aW1nIHNyYz0iaHR0cHM6Ly9pbWcuYWxpY2RuLmNvbS9pbWdleHRyYS9pMS81MDg0Mjg2NS9PMUNOMDFlb2FMOWsxWDJETnV1NlNLZl8hITUwODQyODY1LmpwZyI+PC9kaXY+PGRpdj48aW1nIHNyYz0iaHR0cHM6Ly9pbWcuYWxpY2RuLmNvbS9pbWdleHRyYS9pMi81MDg0Mjg2NS9PMUNOMDF3OXY3YnYxWDJETnZySlJJcl8hITUwODQyODY1LmpwZyI+PC9kaXY+PGRpdj48aW1nIHNyYz0iaHR0cHM6Ly9pbWcuYWxpY2RuLmNvbS9pbWdleHRyYS9pNC81MDg0Mjg2NS9PMUNOMDFaeGFtSVAxWDJETnFwZEJLQl8hITUwODQyODY1LmpwZyI+PC9kaXY+PGRpdj48aW1nIHNyYz0iaHR0cHM6Ly9pbWcuYWxpY2RuLmNvbS9pbWdleHRyYS9pMi81MDg0Mjg2NS9PMUNOMDExYmJvSFYxWDJETno1OFFwU18hITUwODQyODY1LmpwZyI+PC9kaXY+PGRpdj48aW1nIHNyYz0iaHR0cHM6Ly9pbWcuYWxpY2RuLmNvbS9pbWdleHRyYS9pMS81MDg0Mjg2NS9PMUNOMDFMWlZkNHYxWDJEUmFPNWNVUl8hITUwODQyODY1LmpwZyI+PC9kaXY+PGRpdj48aW1nIHNyYz0iaHR0cHM6Ly9pbWcuYWxpY2RuLmNvbS9pbWdleHRyYS9pMi81MDg0Mjg2NS9PMUNOMDEyamRoRmExWDJETnVmZG5pcl8hITUwODQyODY1LmpwZyI+PC9kaXY+
Продавец:淘淘心数码专店
Рейтинг:

Всего отзывов:0
Положительных:0
Выберите вариацию / цвет
- N8 LDS LASER Navigation
- N8Pro DTOF Navigation+3D Структурная оптика доступна
Добавить в корзину
- Информация о товаре
- Фотографии
| Цвет: | N8 LDS LASER Navigation, N8Pro DTOF Navigation+3D Структурная оптика доступна |